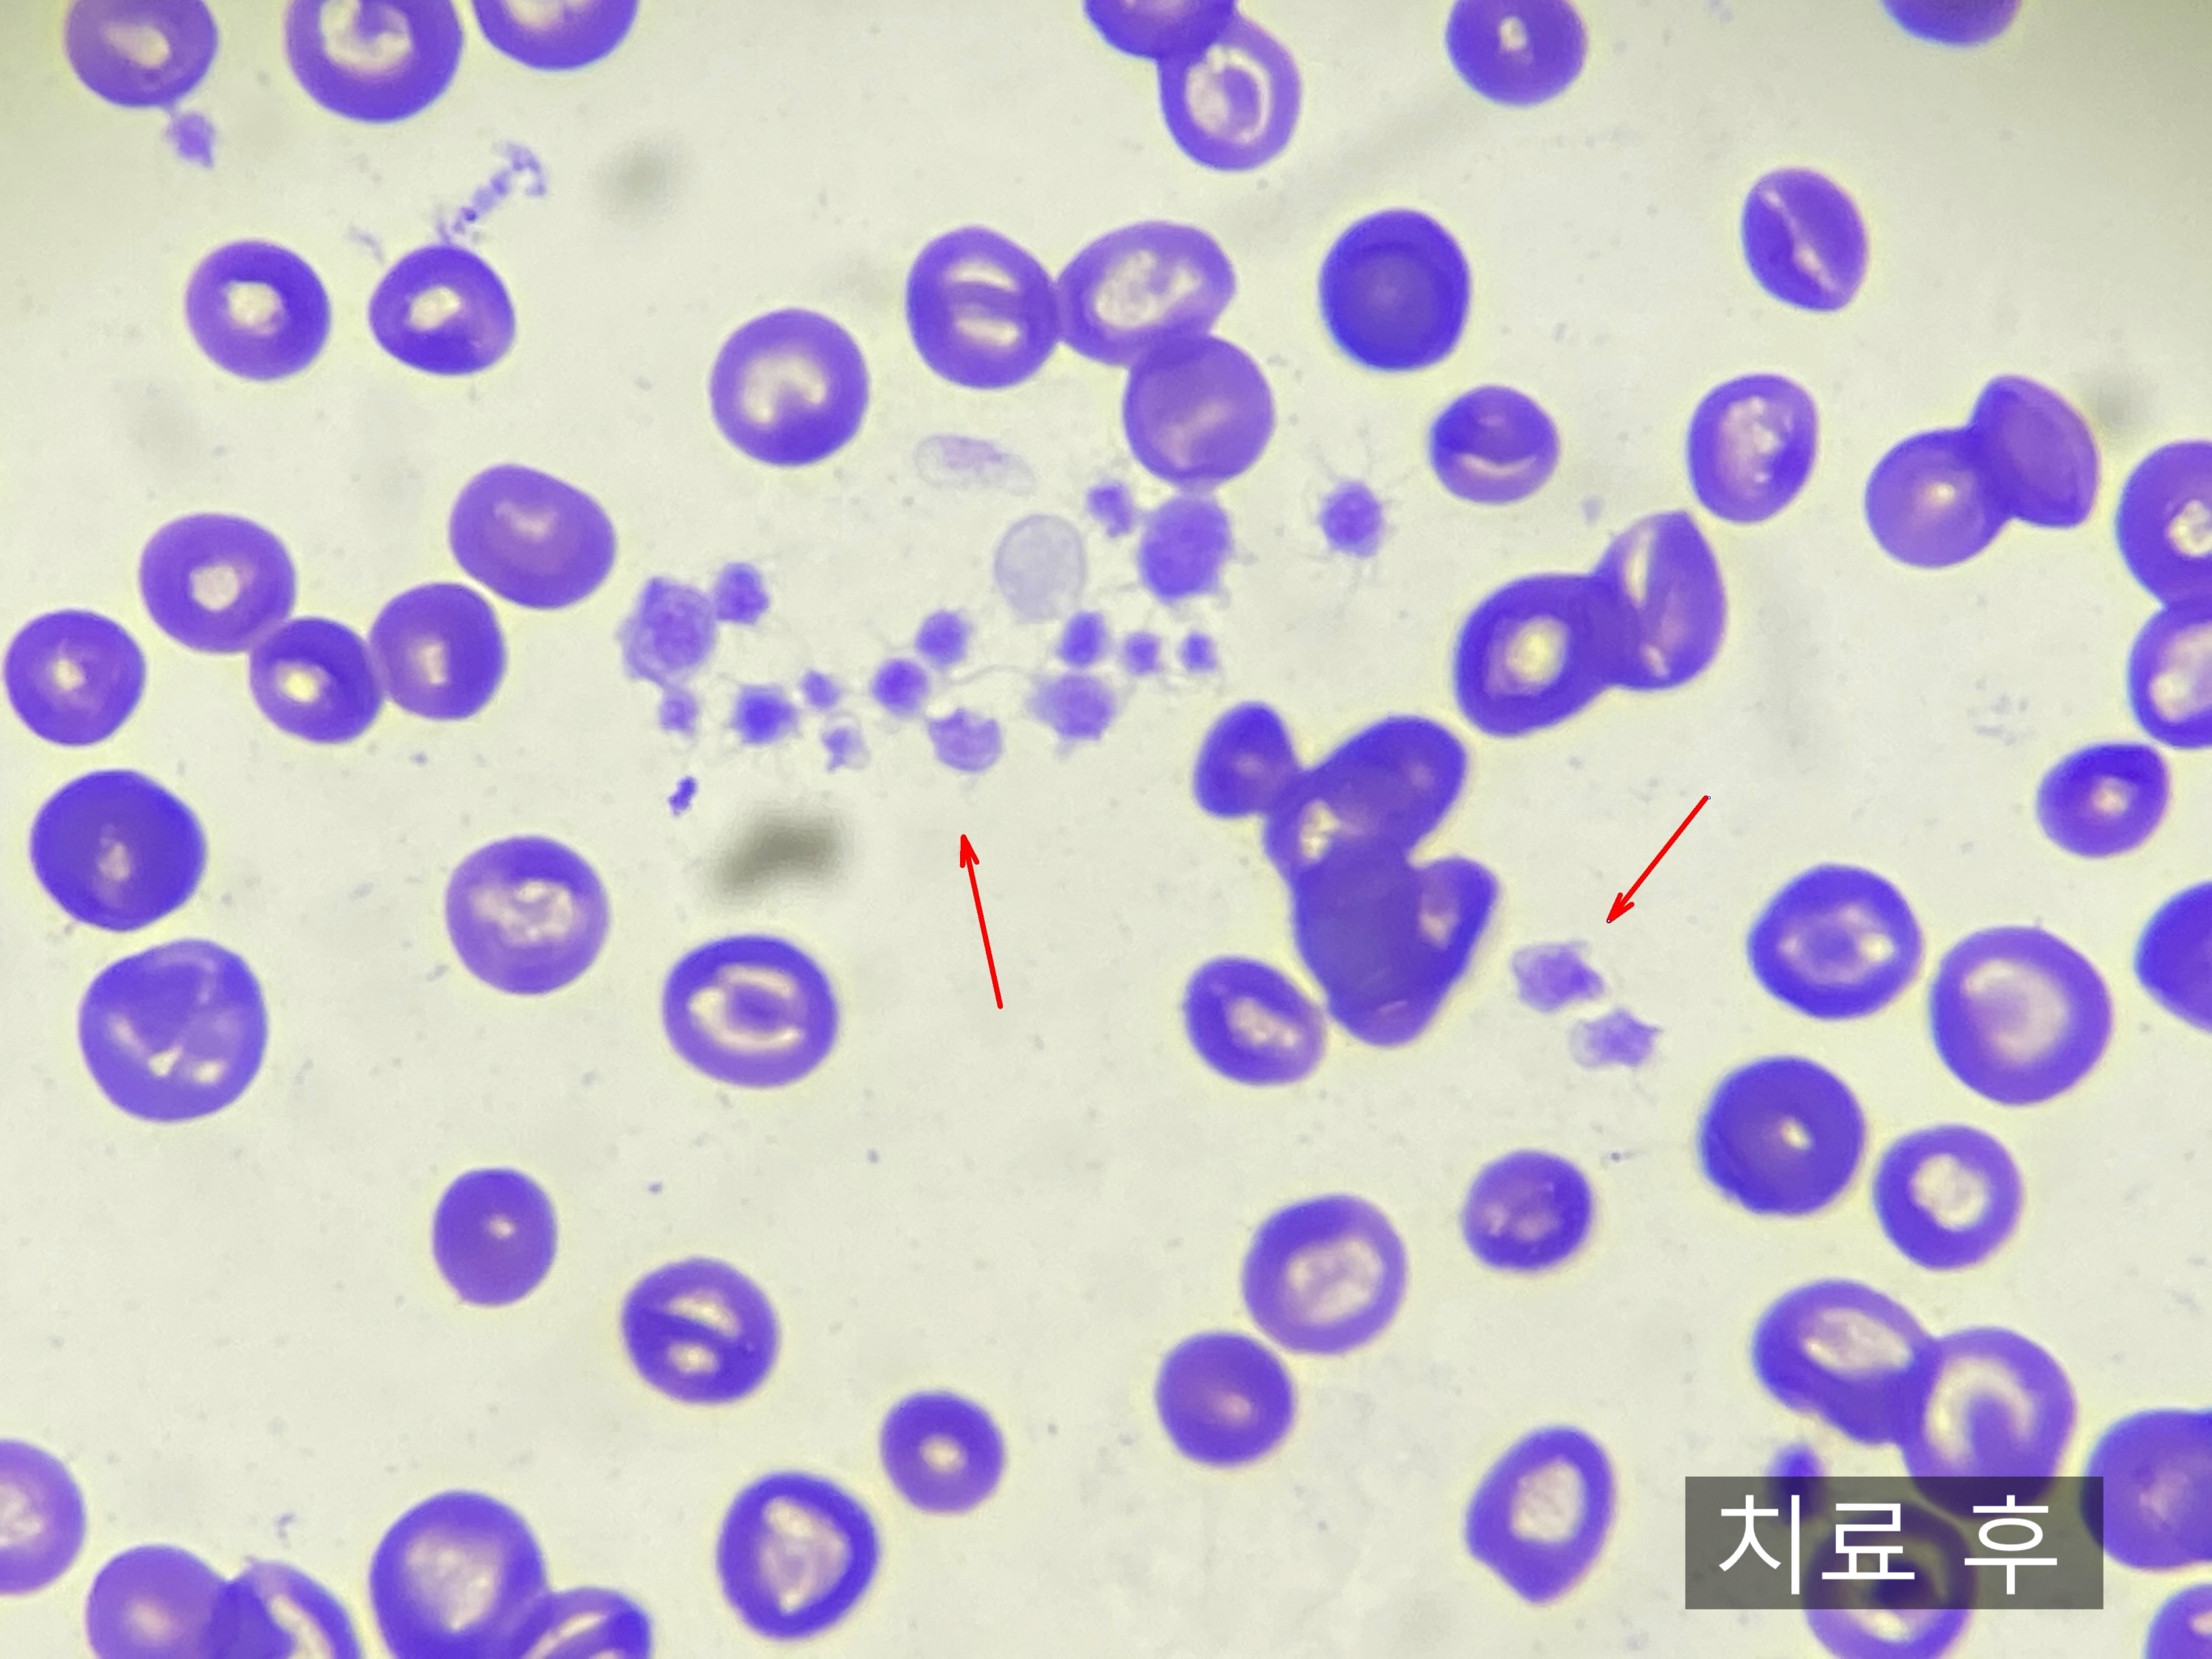

- 등록일2020.10.13
- 조회수19,676

안녕하세요.
반려동물의 따뜻하고 건강한 삶을 위한 잠실24시 잠실on동물의료센터입니다 :)
오늘은 강아지 면역매개성 혈소판감소증으로 치료받은 9살 말티즈 아이 이야기를 잠실24시 동물병원에서 이야기해 드리겠습니다.
< 강아지 면역매개성 혈소판감소증 >
품종 - 말티즈
나이 - 9살
말티즈 아이는 타 병원에서 혈소판 감소증 진단을 받고 치료받던 중 중증의 위장관 출혈에 의한 혈변을 보이며 잠실24시 동물병원으로 내원하게 되었습니다.

내원 당시 혈액 검사에서 혈소판 수치(PLT)가 정상 수치의 20분의 1밖에 되지 않았고, 적혈구 수치 또한 응급 수혈이 필요한 수준의 수치로 극심한 빈혈 상태를 보이고 있었습니다.

응급 수혈을 위해 혈액형 검사를 진행하였고, 강아지 혈액형 중 가장 흔한 혈액형인 DEA 1.1형으로 확인이 되었습니다.
말티즈 아이의 경우 출혈이 멈추지 않으면 위험한 상황으로 진행할 수 있었지만, 응급 수혈을 진행함으로써 응급 상황을 넘길 수 있었습니다.
입원 치료를 통해 절대 안정과 집중 치료가 필요했기 때문에 입원과 함께 약물 처치가 실시되었습니다.

말티즈 아이는 혈소판감소증과 관련한 전염성 질환에 대한 검사에서 모두 음성이 확인이 되었습니다.

최근 사람에게서도 문제가 되고 있는 중증 열성 혈소판 감소증 증후군 바이러스인 SFTSV 검사에서도 최종 음성 판정을 받았습니다.

적극적인 약물 치료를 통해 입원 7일 차 점차 상승하는 적혈구, 혈소판 수치를 확인할 수 있었는데요.

내원 당시 혈액 도말 검사에서 전혀 확인이 되지 않았던 혈소판 또한 확인이 되었습니다 :)
말티즈 아이의 안정화와 빠른 재발을 막기 위해 긴 입원 치료가 유지되었고, 다행히 빠르게 회복되어 건강하게 보호자님 품으로 돌아가게 되었습니다.
재발이 쉽게 일어나는 질환이기 때문에 현재도 정기적인 검사와 집중 모니터링을 통해 관리 중에 있습니다 :)
강아지 면역매개성 혈소판 감소증은
부적절하게 활성화된 면역반응으로 인해 발생하게 됩니다
혈소판은 혈관이 손상되어 피부나 점막 등에 출혈이 발생했을 때 손상된 혈관벽에 붙어 출혈을 막는 아주 중요한 역할을 하는 혈액 속 혈구인데요.
혈액의 응고와 지혈을 담당하는 혈소판이 부적절하게 활성화된 면역 반응으로 인해 발생하게 되며 특발성과 속발성으로 나누어집니다.
특발성의 경우 원인이 정확하지 않은 것으로 알려져 있으며, 속발성의 경우 진드기 바이러스, 감염, 염증, 종양 등에 의해 나타나는 것으로 알려져 있습니다.
면역 매개성 혈소판 감소증의 증상은 이러합니다
강아지가 면역 매개성 혈소판감소증이 병발하게 되면 지혈이 지연되기 때문에 피하출혈, 자반(피멍), 안구 내 출혈, 소화기 출혈로 인한 혈변, 기력저하, 식욕 부진 등이 나타날 수 있습니다.
코카스파니엘, 푸들 등이 호발 품종으로 알려져 있으나 반드시 호발 품종만이 발병하는 질병은 아닙니다 :)
피부가 계속 붉게 보이거나, 붉은 반점 등이 관찰이 된다면 잠실24시 동물병원으로 내원하시어 전문수의사 선생님의 도움을 받아보시기를 권해드립니다.
치료 시기를 놓칠 경우
예후가 굉장히 불량하고 재발이 잦은 질병입니다
강아지 면역 매개성 혈소판감소증은 적절한 시기에 치료할 경우 예후가 좋은 편이지만 치료 시기를 놓칠 경우 예후가 굉장히 불량한 질병 중 하나입니다.
또, 재발이 잦은 질병으로 치료 후에도 정기적인 검사를 통해 강아지의 상태를 모니터링하는 것이 좋습니다.
필요시 약물 치료와 함께 수혈과 입원 치료가 필요할 수 있습니다.
잠실on동물의료센터는 수혈 가능한 병원으로 24시간 내과 전문수의사선생님의 치료와 처치를 받을 수 있습니다 :)
